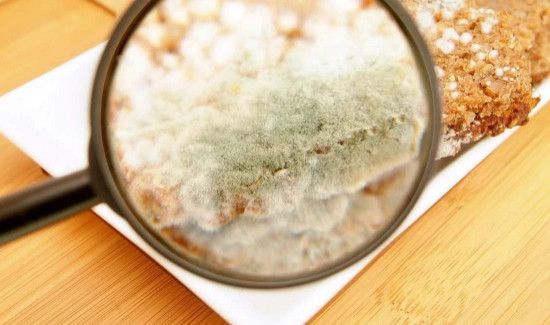
面粉发霉后会产生黄曲霉素吗

面粉发霉后会产生黄曲霉素,且对身体有一定的危害性,如果发霉不严重一定要的话,建议加盐在280°C以上的油温中油炸,去除它的毒性再食用,它的毒性作用比较大,一次大量摄入易导致急性中毒,长期微量摄入易导致慢性中毒。
面粉发霉后会产生黄曲霉素
面粉发霉会产生黄曲霉素,这是一种对身体有害的物质,因此发霉后的面粉最好不要食用,如果一定要吃可以考虑加盐油炸着吃,因为盐中含有的碘化物能去除黄去霉素的部分毒性,280°C以上的油炸高温可以将黄曲霉素的毒性分解掉。
黄曲霉素的毒性比较大,其中以它的B1成分毒性最大,远远超过氰化物、砷化物以及有机农药的毒性,人体大量摄入的时候很可能导致急性中毒,还会引起急性肝炎、出血性坏死等疾病,长期微量摄入可能会造成慢性中毒、影响身体生长。

黄曲霉素除了会在面粉中发霉后滋生外,多生长在土壤、各种动植物、坚果中,容易污染花生、玉米、大豆、小麦等粮食作物,家里自制的发酵食品也会有黄曲霉素,它在高温、湿润的环境下易滋生,超高油温下才能彻底分解。

